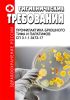
СП 3.1.1.3473-17 Профилактика брюшного тифа и паратифов

- Артикул:00802926
- ISBN: 978-5-907080-26-3
- Обложка: Мягкая обложка
- Город: Москва
- Страниц: 20
- Формат: А5
- Год: 2018
- Вес: 25 г
Документ отменен в связи с изданием Постановления Главного государственного санитарного врача РФ от 28.01.2021 N 4 "Об утверждении санитарных правил и норм СанПиН 3.3686-21 "Санитарно-эпидемиологические требования по профилактике инфекционных болезней"
Взамен СП 3.1.1.2137-06 Профилактика брюшного тифа и паратифов
В соответствии с Федеральным законом от 30.03.1999 N 52-ФЗ "О санитарно-эпидемиологическом благополучии населения" и постановлением Правительства Российской Федерации от 24.07.2000 N 554 "Об утверждении Положения о государственной санитарно-эпидемиологической службе Российской Федерации и Положения о государственном санитарно-эпидемиологическом нормировании" утвердены санитарно-эпидемиологические правила СП 3.1.1.3473-17 "Профилактика брюшного тифа и паратифов".
Санитарно-эпидемиологические правила устанавливают требования к комплексу организационных, профилактических, санитарно-противоэпидемических мероприятий, проведение которых обеспечивает предупреждение возникновения и распространения случаев заболеваний брюшным тифом и паратифами среди населения Российской Федерации.
Содержание
I. Область применения
II. Общие положения
III. Мероприятия по обеспечению федерального государственного санитарно-эпидемиологического надзора за брюшным тифом и паратифами
IV. Выявление случаев брюшного тифа и паратифов
V. Лабораторная диагностика брюшного тифа и паратифов
VI. Противоэпидемические мероприятия при брюшном тифе и паратифах
VII. Порядок выписки, допуска к работе и диспансерное наблюдение лиц, перенесших брюшной тиф и (или) паратифы
VIII. Дезинфекционные мероприятия при брюшном тифе и (или) паратифах
IX. Профилактические мероприятия
X. Гигиеническое воспитание и обучение населения по вопросам профилактики брюшного тифа и паратифов
Артикул 00-01036722